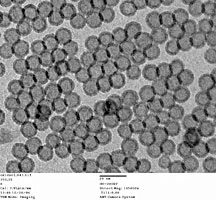

Products
Silicon Nitride Support Films
- Apertures
- Apertures 1,85 x 0,1mm
- Apertures 2,0 x 0,1mm
- Apertures 2,0 x 0,25mm
- Apertures 2,0 x 0,6mm
- Apertures 3,0 x 0,1mm
- Apertures 3,0 x 0,25mm
- Apertures 3,04 x 0,25mm
- Apertures 4,0 x 0,2mm
- Apertures 4,0 x 0,6mm
- Apertures 6.35 x 0.02mm
- Apertures 6,35 x 0,125mm
- Apertures 10,0 x 0,1mm
- Apertures 10,0 x 0,6mm
- Apertures 12,0 x 0,1mm
- Apertures 19,99 x 0,25mm
- Gilded strip apertures
- Multihole Strip Apertures
- Spray Apertures
- Thin Foil Apertures
- Tantalum Wehnelt
- Top Hat Apertures
- Aperture Cleaning
- Brushes
- Calibration
- GSR & Particle Analysis
- Light Microscopy
- SEM Calibration
- (CD) Calibration Test
- Back Scattered Electron Test
- Boron substrates
- Chessy test specimen
- Critical Dimension Magnification Standards
- Demonstration Specimens
- Glass size standards
- Gold on Carbon
- Gold Spheres on Carbon
- Line/Grid Standards
- Low & Medium Magnification
- MRS-3
- MRS-4
- MRS-6
- Multi Calibration Standard
- Polystyrene Spheres
- Silicon test specimen
- Tin on Carbon
- TEM Calibration
- Chemicals
- Cleaning
- Cryo Products
- Desiccators Cabinets
- Diamond Knives
- Dissection
- Embedding
- FIB Supplies
- Filaments
- Forensics
- General Lab Supplies
- Applicator, Sticks and Swabs
- Beakers, Cylinders and Containers
- Cell Strainer System
- Dishes and Boats
- Glass Bottom Dishes
- Laboratory Glassware
- Laboratory Tongs
- Microscopy Illuminators
- Microwave Specimen Holders
- Parafilm M®, Melinex Film
- PELCO Rotators
- Petri Dishes
- Pocket Scales
- Spatulas & Spoons
- Storage Jars, Containers & Bottles
- Thermometers
- Timers
- Ultraviolet Lamps
- Vials, Tubes and Cups
- Wire Mesh
- Gloves
- Grids
- Histology
- Immersion Oils
- Laboratory Tape
- Microscope Slides
- Pipettes and Pipettors
- PTFE Laboratory Products
- Razor- Microtome Blades
- Safety Products
- Slide Boxes, Trays & Mailers
- Slide Labels
- Spatulas and Spoons
- Staining
- Weighing Dishes
- Carbon tabs, tapes & sheets
- Mount Storage Boxes
- Planchets
- Replication Materials
- Scintillators
- Specimen Mount Grippers
- Specimen Preparation Stations
- Starter Kits
- Stubs, Mounts and Holders
- M4 Threaded, Cylinder, and Other Stubs
- Bulk Specimen Holders, M4
- Carbon Planchet Holders, M4
- Carbon, Brass, and Copper Mounts
- Cross Section Holders
- Cylinder Specimen Mounts
- E-Beam Lithography Mount, M4
- EBSD Pre-tilt Holders & Mounts, M4
- Filter Holders, M4
- Flat Sample Clip Holders
- Hitachi T-base Specimen Holders
- Metallographic Mount Holders
- Modular Stage Adapters, M4
- Mount Adapters, M4
- Multipurpose Specimen Holder
- Pin Stub Holders, M4
- Q Pin Mounts and Holders
- Rectangular Mounts
- SEMClamp Holders, M4
- SEMClip Cylinder Mounts
- SEMClip Geological
- STEM Imaging Holder, M4
- TEM Grid Holder, M4
- Tilt Specimen Holders
- Vise Type Holders
- Wafer & Large Sample Holders
- Pin Stubs Specimen Mounts and Holders
- Adapter Buttons
- Angled Pin Stub Holders
- Bulk Specimen Holders with Pin
- Carbon, Brass, and Copper, SEM Mounts
- E-Beam Lithography Mount
- EBSD Pre-tilt Holders & Mounts
- FIB Grid Holders
- Filter Holders, Pin
- Jeol Specimen Holders
- Low Profile FIB Mounts
- Low Profile SEMClip
- Metallographic Mount Holders
- Modular Stage Adapters
- Mount Adapters
- Multi Purpose / Bulk Holders
- Multi-Pin Stub Holders
- Pin Stub Specimen mounts
- Planchet Holders
- Q Pin Stubs and Holders
- Sample Holder Sets
- SEMClamp Holders
- SEMClip Pin Mounts
- Slotted Pin Stubs
- STEM Imaging Holder
- TEM Grid Holders
- Thin Section Holders
- Variable Tilt Holders
- Vise Clamp Holders
- Wafer Holders with Pin
- M4 Threaded, Cylinder, and Other Stubs
- Cabinets for Tissue Cassettes
- Cardboard, Tin Boxes & Cans
- Gel-Pak® Substrate Carriers
- Grid Storage Boxes
- Compact Modular Cabinet
- Plastic Jars, Containers & Bottles
- Membrane Boxes
- Plastic Storage Boxes
- Slide Boxes, Trays and Mailers
- Mount Storage Boxes
- Wafer Carrier Trays
- PELCO X-TREME Cases
- Zipper, Barrier Bags
- Accessories
- Aesculap® – Forceps
- Aquarius Tweezers
- Cantilever Tweezers
- Carbon Fibre tweezers
- Dumont™ Tweezers
- General Purpose Forceps
- Industrial, Economy Tweezers
- Mount Grippers
- PELCO Tweezers
- Plastic Tipped ESD Tweezers
- Plastic Tweezers, Flat & Sharp
- Plastic, Wafer Tip Styles
- Surgical Tissue Forceps
- Wafer Tweezers
- Wafer, Component, Cover Glass
- Wire Cutting Tweezers
- Zirconia Ceramic Tweezers
PELCO® Silicon Nitride Support Films for TEM
8, 15, 35, 50, and 200nm membrane thickness
The PELCO® Silicon Nitride Support Films for TEM (also called Si3N4 TEM membranes) have been developed as an addition to our extensive range of TEM support films to further enable nanotechnology applications and extend molecular biology research.
These superior products are made by state-of-the-art semiconductor and patented MEMS fabrication techniques using resilient, low-stress inorganic and amorphous silicon nitride thin films supported by a sturdy silicon frame.
PELCO® Silicon Nitride Support Films are available in four window sizes combined with either 8, 15, 35, 50nm, or 200nm thin membrane thickness on an EM industry standard 3mm diameter round frame, making them the most desirable and useful silicon nitride support films in the current marketplace.
Silicon Nitride Support Films have the advantages of being chemically and mechanically robust and can withstand temperature changes up to 1000°C. They are extremely stable and suitable to conduct a variety of nanotechnology experiments with particles or cells mounted directly on the support films.
The PELCO® Silicon Nitride Support Films are indispensable tools for virtually all fields of nanotechnology research. They enable direct deposition and in situ observations of dynamic reactions over a wide temperature range. The support film can be used as a passive support film but can also play a role as an active participant in experiments.
Hydrophobic and Hydrophilic Substrates have been added for nanotechnology and biotechnology applications. The ultra-low-stress 15nm, 50nm, and 200nm membranes have been Atomic Layer-Deposited (ALD) to create these surfaces
PELCO® Silicon Nitride Support Films are manufactured using state-of-the-art semiconductor and MEMS manufacturing techniques.
The amorphous Silicon Nitride Support Film is grown on a silicon wafer to the desired membrane thickness of 8, 15, 35, 50, or 200nm.
The specimen viewing area is created by etching away a window in the silicon substrate, leaving a perfectly smooth, resilient and chemically robust silicon nitride film.
The frame is manufactured as a 3mm silicon disc with smooth EasyGrip™ edges for easy manipulation by tweezers and will fit perfectly in standard TEM holders.
Standard thickness of the silicon frame is 200µm which will fit most TEM holders. A special version with a 50µm thickness and a 0.25 x 0.25mm window is available for special TEM holders which only accommodate thinner supports.
Easy handling capabilities and smoothness of the edges are design advantages over other brands of silicon nitride support films.
The PELCO® Silicon Nitride Support Films are manufactured like grids and are completely free from debris particles.

Tomography Type SiN Support Film

Monte Carlo simulations showing less absorption and less scattering in 50nm Silicon Nitride Support Films; Advantage - PELCO®50nm film thickness gives superior imaging and analysis results.
Defining parameters for the PELCO® Silicon Nitride Support Films are:
- Film Thickness: Resilient, ultra-low-stress 8, 15, 35 or 50nm giving rise to minimum absorption to enable clear imaging; robust, low stress 100nm and 200nm for better handling and use on multiple platforms;
- Window Sizes: 0.25 x 0.25mm, 0.5 x 0.5mm, 0.75 x 0.75mm, 1.0 x 1.0mm, 0.5 x 1.5mm and multiple window versions with 9 windows of 0.1 x 0.1mm in a 3 x 3 array or 2 windows of 0.1 x 1.5mm. Larger windows give a greater viewing area and for example, allow for the higher tilt angles required for tomography applications. The versions with the multiple windows allows for mounting multiple samples on separate windows;
- Window/Aperture Size for Ultra-Thin, 8nm Film: Window size is 0.5 x 0.5mm with 25 apertures of 60 x 60µm on a 200nm silicon nitride support mesh. Bar width 35µm, edge 30µm (go to Manufacturing Details).
- Window/Aperture Size for Resilient 35nm Film: Window size is 0.5 x 0.5mm with 25 apertures of 70 x 70µm on a 200nm support mesh. Bar width 25µm, edge 25µm (go to Manufacturing Details).
- Frame Thickness: Silicon support structure is 200µm standard. This allows for fitting in all standard TEM holders and gives a sturdy support frame. 50µm is also available for special TEM holders.
- Surface Roughness: The RMS (Rq) is 0.65 +/- 0.06nm which gives a mean roughness (Ra) of 0.45 +/- 0.02nm;
- Frame Diameter: EM standard 3mm diameter disc, fully compatible with TEM holders and with EasyGrip™ edges for improved handling;
- Packaging: The PELCO® Silicon Nitride Support Films are packaged under cleanroom conditions.
- Orientation: All of our products have <100> orientation with respect to the surface.

single window or multiple windows

9 ea. 0.1 x 0.1mm apertures

2 ea. 0.1 x 1.5mm Apertures

Ultra Thin 8nm


Applications Fields:
- Cell biology: attached cells can be grown in their environment on the support film and subsequently analyzed
- Analysis of colloids, aerosols, nanoparticles
- Self-assembled mono-layers
- Polymer research
- Thin film research (directly deposited on the Silicon Nitride Support Film)
- Materials science
- Properties of nano-structures for semiconductor devices
- Semiconductor: characterization of thin films
- Catalyst development
| Art. | Description | Unit | Price | Quantity | |
|---|---|---|---|---|---|
| 21510-10 | Silicon Nitride Support Film, 8nm, 60×60 m Apertures (25) on 0.5 x 0.5mm Window | 10 | € 513,40 |
| Art. | Description | Unit | Price | Quantity | |
|---|---|---|---|---|---|
| 21560-10 | Silicon Nitride Support Film, 15nm with 0.25 x 0.25mm Window | 10 | € 347,70 | ||
| 21568-10 | Silicon Nitride Support Film, 15nm with 2 each 0.1 x 1.5mm Windows | 10 | € 347,70 | ||
| 21569-10 | Silicon Nitride Support Film, 15nm with 9 each 0.1 x 0.1mm Windows | 10 | € 347,70 |
| Art. | Description | Unit | Price | Quantity | |
|---|---|---|---|---|---|
| 21515-10 | Silicon Nitride Support Film, 35nm, 70×70 m aperture (25) on 0.5 x 0.5mm Window | 10 | € 282,60 |
| Art. | Description | Unit | Price | Quantity | |
|---|---|---|---|---|---|
| 21505-10 | Silicon Nitride Support Film, 50nm with 0.25 x 0.25mm Window | 10 | € 230,40 | ||
| 21505-100 | Silicon Nitride Support Film, 50nm with 0.25 x 0.25mm Window | 100 | € 2.008,50 | ||
| 21500-10 | Silicon Nitride Support Film, 50nm with 0.5 x 0.5mm Window | 10 | € 230,40 | ||
| 21500-100 | Silicon Nitride Support Film, 50nm with 0.5 x 0.5mm Window | 100 | € 1.910,00 | ||
| 21501-10 | Silicon Nitride Support Film, 50nm with 0.75 x 0.75mm Window | 10 | € 240,30 | ||
| 21501-100 | Silicon Nitride Support Film, 50nm with 0.75 x 0.75mm Window | 100 | € 1.969,20 | ||
| 21502-10 | Silicon Nitride Support Film, 50nm with 1.0 x 1.0mm Window | 10 | € 240,30 | ||
| 21502-100 | Silicon Nitride Support Film, 50nm with 1.0 x 1.0mm Window | 100 | € 2.067,60 | ||
| 21504-10 | Silicon Nitride Support Film, 50nm with 0.5 x 1.5mm Window | 10 | € 230,10 | ||
| 21504-100 | Silicon Nitride Support Film, 50nm with 0.5 x 1.5mm Window | 100 | € 2.067,60 | ||
| 21508-10 | Silicon Nitride Support Film, 50nm with 2 each 0.1 x 1.5mm Windows | 10 | € 233,40 | ||
| 21509-10 | Silicon Nitride Support Film, 50nm with 9 each 0.1 x 0.1mm Windows | 10 | € 233,40 |
| Art. | Description | Unit | Price | Quantity | |
|---|---|---|---|---|---|
| 21570-10 | Silicon Nitride Support Film, 50nm on 50 m frame thickness with 0.25 x 0.25mm Window | 10 | € 358,60 | ||
| 21578-10 | Silicon Nitride Support Film, 50nm on 50 m frame thickness with 2 each 0.1 x 1.5mm Windows | 10 | € 394,20 | ||
| 21579-10 | Silicon Nitride Support Film, 50nm on 50 m frame thickness with 9 each 0.1 x 0.1mm Windows | 10 | € 394,20 |
| Art. | Description | Unit | Price | Quantity | |
|---|---|---|---|---|---|
| 21516-10 | Silicon Nitride Support Film, 100nm with 0.25 x 0.25mm Window | 10 | € 174,40 | ||
| 21517-10 | Silicon Nitride Support Film, 100nm with 0.1 x 1.5mm (2) Windows | 10 | € 174,40 | ||
| 21519-10 | Silicon Nitride Support Film, 100nm with 0.1 x 0.1mm (9) Windows | 10 | € 174,40 | ||
| 21513-10 | Silicon Nitride Support Film, 100nm with 1.0 x 1.0 Window | 10 | € 185,20 | ||
| 21511-10 | Silicon Nitride Support Film, 100nm with 0.5 x 0.5mm Window | 10 | € 174,40 | ||
| 21512-10 | Silicon Nitride Support Film, 100nm with 0.75 x 0.75mm Window | 10 | € 185,20 | ||
| 21514-10 | Silicon Nitride Support Film, 100nm with 1.5 x 0.5mm Window | 10 | € 185,20 |
| Art. | Description | Unit | Price | Quantity | |
|---|---|---|---|---|---|
| 21525-10 | Silicon Nitride Support Film, 200nm with 0.25 x 0.25mm Window | 10 | € 187,80 | ||
| 21525-100 | Silicon Nitride Support Film, 200nm with 0.25 x 0.25mm Window | 100 | € 1.576,10 | ||
| 21520-10 | Silicon Nitride Support Film, 200nm with 0.5 x 0.5mm Window | 10 | € 187,80 | ||
| 21520-100 | Silicon Nitride Support Film, 200nm with 0.5 x 0.5mm Window | 100 | € 1.575,30 | ||
| 21521-10 | Silicon Nitride Support Film, 200nm with 0.75 x 0.75mm Window | 10 | € 184,80 | ||
| 21521-100 | Silicon Nitride Support Film, 200nm with 0.75 x 0.75mm Window | 100 | € 1.595,00 | ||
| 21522-10 | Silicon Nitride Support Film, 200nm with 1.0 x 1.0mm Window | 10 | € 184,80 | ||
| 21522-100 | Silicon Nitride Support Film, 200nm with 1.0 x 1.0mm Window | 100 | € 1.595,00 | ||
| 21524-10 | Silicon Nitride Support Film, 200nm with 0.5 x 1.5mm Window | 10 | € 184,80 | ||
| 21524-100 | Silicon Nitride Support Film, 200nm with 0.5 x 1.5mm Window | 100 | € 1.673,10 | ||
| 21528-10 | Silicon Nitride Support Film, 200nm with 2 each 0.1 x 1.5mm Windows | 10 | € 183,10 | ||
| 21529-10 | Silicon Nitride Support Film, 200nm with 9 each 0.1 x 0.1mm Windows | 10 | € 183,10 |
Description
PELCO Hydrophilic and Hydrophobic Silicon Nitride Membrane Surfaces
15nm, 50nm and 200nm membrane thickness
Hydrophobic and Hydrophilic Silicon Nitride Membrane
Silicon Nitride membranes have been modified using Atomic Layer-Deposited (ALD) techniques to change their surface properties.
Depending on the process used, both Hydrophilic and Hydrophobic substrates have been created with the following advantages:
- Choice between low and high surface energies
- Smooth and conformal substrates
- Enhanced wetting and biocompatibility (hydrophilic)
- No need for plasma treatment of surface prior to cell growth
- Hydrophobic coating offers novel platform for deposition and growth of nanomaterials
Hydrophobic surfaces improve sample preparation for materials that are dissolved or suspended in organics solvents.
Nanoparticles in organic solvents (such as carbon nanotubes) will readily disperse on the Silicon Nitride membrane surface.
Hydrophilic surfaces enhance wetting and dispersion of aqueous solutions. This avoids particle aggregation effects commonly observed on less hydrophilic surfaces. Particularly useful in water based sols and life science applications.
Both coatings are available on 50nm and 200nm PELCO Silicon Nitride Membranes with a 0.5 x 0.5mm window and 15nm Si3N4 membrane with 9 each 0.1 x 0.1nm windows on a 200 m silicon frame with a diameter of 3mm, compatible with all standard TEM grid holders. Both sides of the membrane and frame are coated.
We advise to handle the discs by gripping at the edge.
Specifications:
Hydrophilic: 2.5nm atomic layer-deposited hydroxylated alumina on 15, 50 and 200nm ultra-low-stress silicon nitride membrane
Hydrophobic: 2.5nm atomic layer-deposited alumina and fluoro-methyl-silane on 15, 50 and 200nm ultra-low-stress silicon nitride membrane
Surface Energy:
| Surface | Surface Energy (mJ/m2) | Standard Deviation |
| Silicon Nitride Membrane | 46.1 | 4.3 |
| Hydrophilic Coating | 76.1 | 2.2 |
| Hydrophobic Coating | 24.6 | 4.4 |
| mj= millijoules | ||
- Surface Roughness:
| Surface | Surface Roughness (nm) | Standard Deviation |
| Silicon Nitride Membrane | Rq=0.65 Ra=0.45 | 0.06 0.02 |
| Hydrophilic Coating | Rq=0.57 Ra=0.40 | 0.04 0.03 |
| Hydrophobic Coating | Rq=0.66 Ra=0.40 | 0.03 0.05 |
| Rq= Surface Roughness; Ra= Roughness Average | ||
- Film Thickness: Resilient, low stress 15, 50 and 200nm, giving rise to minimum absorption to enable clear imaging
- Window Sizes: Array of 9 ea. 0.1 x 0.1mm and 0.5 x 0.5mm
- Frame Thickness: Silicon support structure is 200 m standard.
- Frame Diameter: EM standard 3mm diameter disc, fully compatible with standard TEM holders (no broken edges)
- EasyGrip Edges for easy handling with tweezers
- Packaging: The PELCO Silicon Nitride Support Films are packaged under cleanroom conditions in the PELCO #160 TEM Grid Storage box. Each box holds 10 support films.
| Art. | Description | Unit | Price | Quantity | |
|---|---|---|---|---|---|
| 21553-10 | PELCO Hydrophilic 15nm Silicon Nitride Membrane, 9 ea. 0.1×0.1mm Windows | 10 | € 427,80 | ||
| 21550-10 | PELCO Hydrophilic 50nm Silicon Nitride Membrane, 0.5 x 0.5mm Window | 10 | € 326,00 | ||
| 21551-10 | PELCO Hydrophilic 200nm Silicon Nitride Membrane, 0.5 x 0.5mm Window | 10 | € 282,50 | ||
| 21593-10 | PELCO Hydrophobic 15nm Silicon Nitride Membrane, 9 ea. 0.1 x 0.1mm Windows | 10 | € 427,80 | ||
| 21552-10 | PELCO Hydrophobic 50nm Silicon Nitride Membrane, 0.5 x 0.5mm Window | 10 | € 326,00 | ||
| 21591-10 | PELCO Hydrophobic 200nm Silicon Nitride Membrane, 0.5 x 0.5mm Window | 10 | € 282,50 |